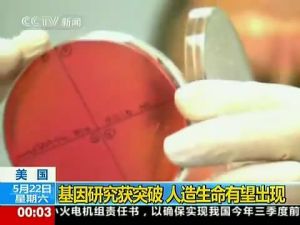
人造單細胞生物

人造單細胞生物問世

美國J·克雷格·文特爾研究所的研究人員在最新一期美國《科學》雜誌上報告說,他們人工合成了一種名為蕈狀支原體的細菌的脫氧核糖核酸(DNA),並將其植入另一個內部被掏空的、名為山羊支原體的細菌體內。經過多次失敗的嘗試後,最終他們使植入人造DNA的細菌重新獲得生命,並開始在實驗室的培養皿中繁殖。
“這是第一個人造細胞,”領導研究的克雷格·文特爾說,“這是地球上第一個父母是電腦、卻可以進行自我複製的物種。”
許多科學家積極評價這一成果,但也不乏擔憂的聲音。美國賓夕法尼亞大學生物倫理學家阿瑟·卡普蘭在《自然》雜誌上評論說,文特爾的成果終止了有關生命的存在是否需要特殊力量或能量的爭論。“在我看來,這使它成為人類歷史上最重要的科研成果。”
美國波士頓大學生物醫學工程教授吉姆·柯林斯則反駁說,“這項成果破壞了我們有關生命屬性的基本信念,而這種信念對我們如何看待(人類)自己、如何看待我們在宇宙中的位置都非常重要”。
還有一些人擔心這項技術可能被用於製造生物武器。環保組織“地球之友”成員埃里克·霍夫曼表示,必須確保相關的法規到位,以保護環境和人類健康免受這項有潛在危險的新技術的傷害。
父母是電腦的物種
“這是第一個人造細胞,”領導研究的克雷格·文特爾說,“這是地球上第一個父母是電腦、卻可以進行自我複製的物種,它是一個活生生的物種,是我們這個星球上生命中的一部分。”

雖然實驗原理聽起來很簡單,但是科研人員在15年間花費4000萬美元才得以成功,其中的難點就在於如何讓人造基因序列生成人造染色體。科學家經過多年反覆的實驗,終於攻克了所有技術難題,製造出了“人造生命”。文特爾將“人造生命”起名為“辛西婭”。
項目組其他成員表示,這僅僅是一個更宏大工程的一小步,未來他們甚至可以根據客戶需求提供“訂製”的有機物。此外,未來科學家還可以製造出能夠產出石油或專以二氧化碳為食的環境友好型“人造生命”。據悉,文特爾已經和石油巨頭埃克森美孚達成協定,要製造一種可以吸收二氧化碳並將其轉化為燃料的水藻。
文特爾自信地說,“人造生命”將成為非常強大有用的生物學工具。他預計,這項發明的價值超過萬億美元。
文特爾稱,在實驗開始前他已經請教過許多倫理領域的專家,並向白宮匯報過此事。

目前,歐巴馬已經敦促生物倫理委員會督察此事,“評估此研究將給醫學、環境、安全等領域帶來的任何潛在影響、利益和風險,並向聯邦政府提出行動建議,保證美國能夠在倫理道德的界限之內、以最少的風險獲得此研究成果帶來的利益”。
關於J·克雷格·文特爾
被很多人稱為生物學界“壞小子”的文特爾是塞雷拉基因組公司的創辦人與前任總裁,此公司在他的帶領下展開與人類基因組計畫互相競爭、且具有商業目的之研究計畫,此後他逐漸成名。《時代》雜誌在2007年將文特選為世界上最有影響力的人之一。
因為性格張揚,美國生物學家克雷格·文特爾被很多人稱為生物學界的“壞小子”,他曾經公然挑戰“國際人類基因組計畫”,想將人類基因組圖譜申請成專利並從中牟利;現在,他又利用基因技術製造出首個“人造單細胞生物”.面對人們的指責,文特爾依然我行我素。
5月20日,《科學》雜誌上公布了文特爾的最新成果:他在實驗室中通過化學合成“絲狀支原體絲狀亞種”的DNA,並將其植入去除了遺傳物質的山羊支原體體內,創造出世界上首個“人造單細胞生物”.這個被命名為“辛西婭”(Synthia)的生物立即給公眾帶來了驚嘆、爭議和恐慌。
但在學術沙龍上,多位專家指出,媒體中廣為使用的“首次合成人工生命”之說,並不準確。文特爾的成功之處,在於用化學試劑合成了人工染色體,並在另一微生物中顯示出生物功能。DNA是決定生物性狀的遺傳密碼,卻不是生命的唯一組成部分。
從這個意義上講,文特爾只不過創造了部分生命。這項研究成果最為直接的意義,只是人造的支原體可以利用化學合成的染色體生存繁殖,並導致山羊的乳腺炎。“首次創造生命”之說言之過甚。

事實上,文特爾本人在《科學》雜誌上發表的文章題目卻更為客觀、嚴謹:“首次合成由化學合成基因組控制的細菌”.《科學》雜誌的相關評論指出,這項研究成果其實並不是首次創造新的生命形式,科學的定義應該是“生命再創造”或“篡改生命”.因為辛西婭除了染色組是人工合成外,生命體的其他組分均是來自於已有生命形式。
但正如許多媒體中的評價所言,無論如何這項耗資4000萬美元的科技成果,畢竟是人類生命科學發展的一大進步。英國《經濟學人》將此成果與上個世紀核子彈的誕生相提並論。
專家觀點
當國內外的生物學家們為文特爾的新成果感到歡欣鼓舞時,辛西婭的出現卻給公眾帶來了恐慌。
有人擔心業餘愛好者們的行為:今天,只要有5萬美元,就可以裝備一個二手設備的生物技術家庭實驗室;在英特網上,已經有網頁在教授從細胞中分離DNA以及在紫外線下製造發光菌,人們不受限制地接觸這些信息會產生什麼樣的後果將難以預料。

有專家坦承,人工合成的生物系統一旦逃逸到自然界,可能會引發生態災難;恐怖分子可能會利用合成生物學技術製造生物(基因)武器,造成重大人員傷亡。合成生物學的研究比當前的轉基因技術、基因工程等更為前衛,產生的社會效益與風險也是一把雙刃劍。
中科院院士、中國科學院北京基因組研究所楊煥明研究員十分擔心這種輿論會阻礙我國合成生物學發展的腳步。“那樣的話,會真正拉開發達國家和開發中國家的距離,使我們陷入非常尷尬的局面。”
他認為,科學本身的倫理性不可否認,沒有科學的發展就沒有人類的進程。如果有人利用科學去做不合倫理、不道德的事情,那不是科學本身的錯。現在的生物實驗室里也有許多可能會危害人類的細菌、病毒等,但因為有相關的管理措施,也沒有發生人們想像的恐怖事件。在他看來,道德、倫理方面的問題與科學技術發展不應該是互相排斥的。
對於公眾的恐慌和擔心,軍事醫學科學院生物工程研究所凌焱副研究員說,這些技術被用於真正創造人造生命,其實還有很遠的路。畢竟,創造人工生命遠不像拼接電路、壘積木那樣簡單。曾有報導說,這也正是人類基因組破譯十年後,其研究成果不能直接套用於醫療的原因。

《經濟學人》雜誌認為,人造生命看起來是一件令人驚奇的事,這種技術具有眾多優勢。就短期而言,可以套用於製造更好的藥物、農產品、綠色燃料以及促進化學工業的發展;但從長期來看,誰也不知道它可能帶來什麼樣的後果,這種技術與生俱來地存在著危險,如果濫用可能導致恐怖的災難。
反應不一
美國賓夕法尼亞大學生物倫理學教授阿瑟·卡普蘭在《自然》網站上發表評論說,文特爾等人的成就顛覆了對生命性質的根本信念,其重大意義或許可以同伽利略、哥白尼、達爾文和愛因斯坦的發現相提並論。

不過,有人認為文特爾等人有些誇大其詞。美國《新聞周刊》一篇文章認為,文特爾等人培育出的細胞是否真的算人工合成仍然值得商榷,因為他們並非憑空編寫出這個新細胞的基因代碼,而是使用一套現成代碼加以改動。《華盛頓郵報》則評論說,文特爾只提供了基因,而沒有提供讓它們存在的環境。受體細胞是經過數十億年進化的天然產物。有了它,基因的存在才有意義。
生物工程一直備受爭議。人們擔心不遵守生命進化自然規則的人造生命,可能摧毀自然界中的生物,甚至人類自身。在實驗室里製造新型微生物時,很可能某些環節出錯,造出一些意想不到的“怪胎”。如果人造生命的技術落入恐怖主義分子手中,可能被用於製造致命病毒或生化武器。
從社會倫理角度看,人造生命技術是對人類發展的干預,可能影響人種的自然構成和發展。從家庭倫理角度看,可能瓦解正常的人倫秩序,使人喪失基本的歸屬感。環保組織“地球之友”在文特爾研究所報告發布後稱人工合成基因組是一項“危險的新技術”,要求文特爾“停止進一步研究直至有足夠監管措施”。
對此,文特爾已表示不必擔心他們的研究成果會危害環境,理由是:研究人員在培育由人工合成基因組控制的細胞時,把細胞設計成離開實驗室環境就無法存活的生命形式;而且細胞本身無比脆弱,只要在遺傳密碼中出現一個極小錯誤,細胞就失去自我複製功能。
專家呼籲
在合成生物學發展的這幾年時間裡,在各種科學刊物及學術會議上,有關合成生物學與生物安全、倫理道德及智慧財產權的話題也是經常討論的重要議題。美國眾議院能源和商務委員會5月27日還專門就合成生物學舉行了聽證會。

但與此同時,美國、歐盟並沒有放緩發展的腳步,他們不斷加大合成生物學領域研究的投入。美國國家自然科學基金會(NSF)2006年投入2000萬美元資助建立合成生物學工程研究中心,由UCB、哈佛大學、MIT、加州大學舊金山分校(UCSF)等共同組建。歐盟2007年啟動了“合成生物學--新的及剛出現的科學技術引導項目”.
美國的聽證會最終得出的結論是,合成生物技術目前還不會引起環境、安全及倫理方面的擔憂,但需要關注其發展。作證的科學家們認為,如果提供良好的監管環境,假以時日,合成生物學將在開發清潔燃料、新疫苗及廉價藥品等領域得到廣泛套用。
這也正是美國資源部傾資300萬美元支持文特爾研究人工生命的真正用意。
當前,合成生物學的產業化套用已經初現端倪,據報導,美國兩家企業已開始使用人工細菌生產生物燃料,製藥公司賽諾菲-安萬特公司已經獲準使用合成生物學改造的啤酒酵母生產青蒿素。

楊煥明認為,美國的做法值得我們學習,那就是鼓勵發展,同時制定細緻有效的政策規範。他呼籲我國也應該立即行動,積極投入人造生命的研究領域,至少獲得不落後於美國的技術水平。
中國醫學科學院副院長詹啟敏也認為,對合成生物學帶來的生物安全問題如何控制,要提早準備,但並不是被聳人聽聞的輿論嚇住停滯下來,不去發展。
在加拿大阿爾伯塔大學法學院杜立博士看來,科學界和法學界是存在鴻溝的,這個鴻溝就導致中國目前有關科技的立法都非常滯後。“現在合成生物學處在非常初級的階段。我們越早介入探討它發展需要的政策措施,就會越利於此學科今後在國際上地位的確立。”
